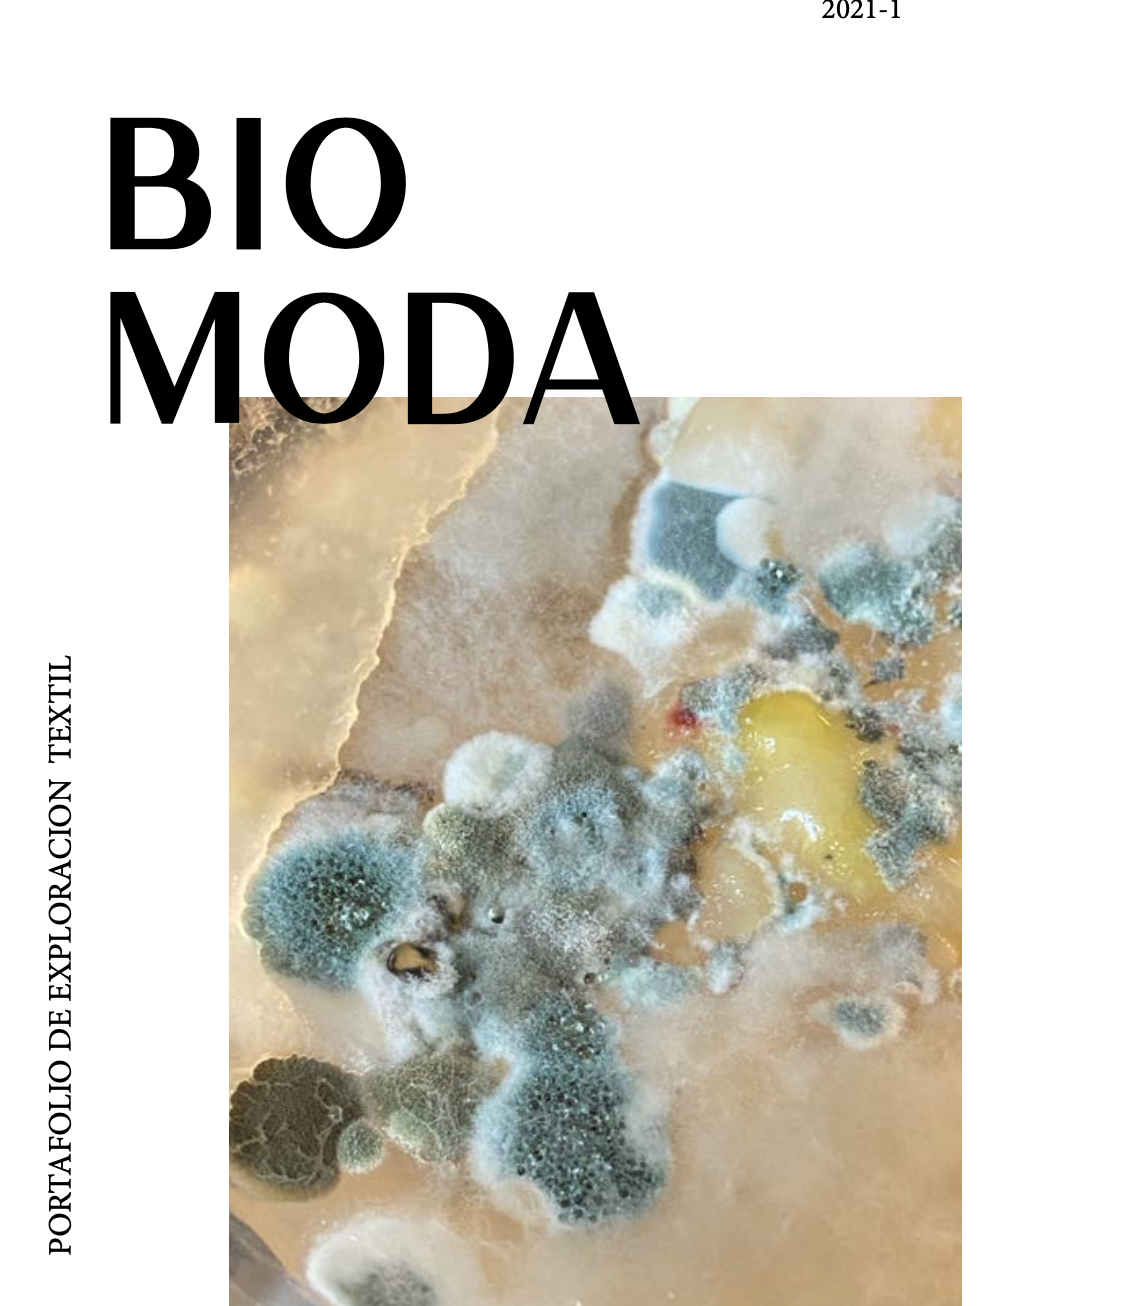

Hola! Me llamo Maria Velez Florez.
Soy diseñadora con énfasis en Producto de la Universidad De Los Andes. Complemente mis estudios con el titulo de Emprendimiento en Administracio de empresas y en Diseño Textil.
Mi metodología de trabajo se estructura en el Design Thinking, lo cual garantiza la innovación y calidad.
Considero que la clave para tener un exelente producto final es el trabajo en equipo. Poder involcrar al usuario objetivo todas las partes del proceso creativo; y estar abirto a la constante reiteracion. Esto abre puentes de comunicación que resultan en un producto que sobre sale en el mercado.
Hoy en dia las megacorporaciones se interesan principalmente en generar productos para vender en masa, cuando el verdadero objetivo de diseno es investigar al profundidad e iterpretar las necesidades especificas de la audiencia y cumplir el objetivo planteado por el cliente.
Esta soy yo, el vestido de baño que llevo puesto es de mi autoría para la marca BOLG Swimwear. Realice pintura en acuarela de flora nacional. Cree el diseno de las prendas, realice digitalmente patrones para sublimar el textil que luego fue confeccionado por manos Colombianas.
Desde temprana edad he generado gran curiosidad la responsabilidad individual que tenemos frente a las comunidades diversas y el medio ambiente. Al estudiar diseño me enamoré de la sostenibilidad, reconociendo que desde la práctica profesional disruptiva podemos generar los cambios necesarios para reparar y construir un futuro.
Ciencia
Tanto el método científico como el design thinking cumplen una función paralela. Por medio de la investigación ardua la aplicacion y reiteracion se abre el epacio a ideas novedosasy practicas eficientes.
Sostenibilidad
Nuestros ecosistemas están desapareciendo debido a la excesiva explotación de recursos. Es la responsabilidad de todos garantizar la creación de procesos para mitigar las repercusiones ambientales que se están presentando a nivel global.
Empatia
Las causas sociales son una temática transversal. Me gusta explorar desde mis habilidades como diseñadora, me gusta en proyectos que se vinculen con el apoyo a comunidades marginalizada, diversidad de raza, Derechos de la Mujer y las comunidades Genero y sexo diversas.
-

-

-

-
-

-

-

-

-

Ilustració
-

-
